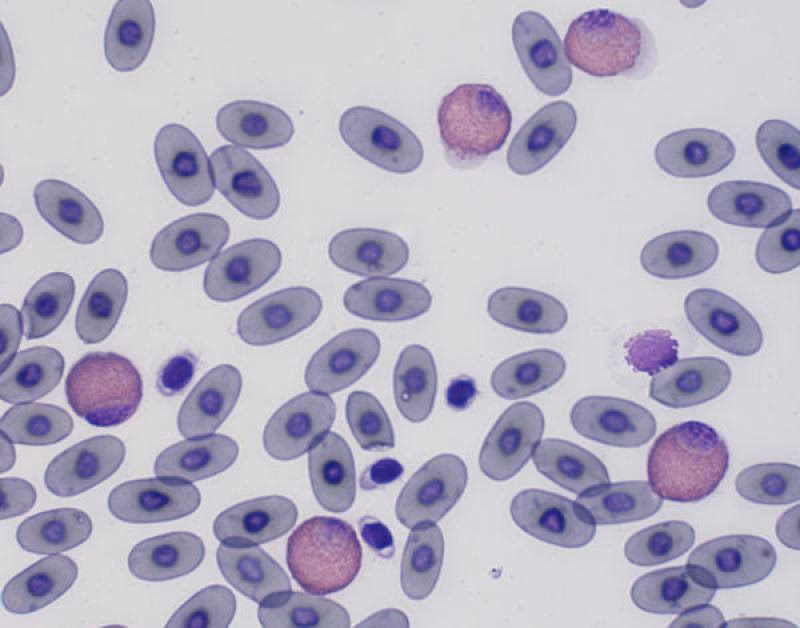
¿Qué es la hemoglobina en un conejo?

19/06/2008
La salud de nuestros queridos conejos depende de una compleja red de sistemas trabajando en armonía. Uno de los más cruciales, aunque a menudo invisible a simple vista, es el sistema circulatorio y, dentro de él, los componentes que forman la sangre. La sangre ha sido llamada, con razón, el río de la vida, transportando todo lo necesario para que cada rincón del cuerpo funcione correctamente, desde los órganos vitales hasta la punta de sus orejas.
En este río vital, navegan diferentes tipos de células, cada una con una misión específica. Pero hoy, nos centraremos en los protagonistas silenciosos pero fundamentales: los eritrocitos, más conocidos como glóbulos rojos. Entender qué son y qué hacen nos ayuda a comprender mejor la salud general de nuestro pequeño amigo peludo. Los eritrocitos son, simplemente, los glóbulos rojos. Son el tipo de célula más abundante en la sangre de los mamíferos, y nuestros conejos no son la excepción. Aunque parezcan simples a primera vista, su estructura está perfectamente diseñada para una tarea esencial: el transporte de oxígeno. Cada glóbulo rojo contiene una proteína especial llamada hemoglobina, que es la encargada de capturar el oxígeno en los pulmones y liberarlo donde los tejidos del cuerpo lo necesitan. Imagina el cuerpo de tu conejo como una gran ciudad que necesita un suministro constante de energía. El oxígeno es como el combustible que alimenta todas las actividades, desde los saltos juguetinos hasta la digestión de su heno. Los eritrocitos actúan como los camiones de reparto que llevan este combustible vital a cada célula. Sin un suministro adecuado de oxígeno, las células no pueden producir la energía necesaria para funcionar, lo que afecta a todos los órganos y sistemas. Pero su trabajo no termina ahí. Una vez que entregan el oxígeno, los eritrocitos también recogen el dióxido de carbono, un producto de desecho del metabolismo celular. Lo transportan de regreso a los pulmones, donde es exhalado. Es un intercambio constante, un ciclo vital que mantiene equilibrado el funcionamiento interno. Cuando llevas a tu conejo al veterinario, es posible que en algún momento le realicen un análisis de sangre. Dentro de este análisis, uno de los parámetros que se miden es la cantidad de glóbulos rojos que tiene. Esto es lo que se conoce como un examen de eritrocitos o, más comúnmente, parte de un hemograma completo. Este examen mide cuántos glóbulos rojos hay en un volumen determinado de sangre. ¿Por qué es importante este número? Porque la cantidad de oxígeno que los tejidos corporales de tu conejo reciben depende directamente de cuántos glóbulos rojos tenga y de qué tan bien estén funcionando (es decir, cuánta hemoglobina contienen). Un número anormal de eritrocitos puede ser un indicador temprano de varios problemas de salud. Si el número de glóbulos rojos es demasiado bajo, la condición se llama anemia. La anemia significa que no hay suficientes "camiones de reparto" para llevar el oxígeno necesario, lo que puede causar debilidad, letargo y otros síntomas relacionados con la falta de oxígeno en los tejidos. Si, por el contrario, el número es demasiado alto (una condición menos común llamada policitemia), la sangre puede volverse demasiado espesa, dificultando su circulación. Por lo tanto, un examen de eritrocitos no es solo un número; es una herramienta diagnóstica crucial que ayuda al veterinario a evaluar la capacidad de la sangre de tu conejo para transportar oxígeno y detectar posibles enfermedades subyacentes que afecten la producción o la vida útil de estas células. ¿Dónde se producen estas células tan importantes? La respuesta está en un lugar sorprendente: la médula ósea roja, que se encuentra dentro de algunos huesos grandes. La médula ósea es una especie de fábrica biológica increíblemente eficiente. Todo comienza con células madre especiales, llamadas hemocitoblastos. Estas células son como la "materia prima" que puede diferenciarse y convertirse en cualquiera de los diferentes tipos de células sanguíneas, incluyendo los glóbulos rojos, los glóbulos blancos (que defienden el cuerpo de infecciones) y las plaquetas (que ayudan en la coagulación). Si un hemocitoblasto recibe las señales adecuadas, se embarca en un camino de desarrollo para convertirse en un glóbulo rojo. Pasa por varias etapas, una de las cuales es convertirse en una célula llamada proeritroblasto. Este proceso, desde la célula madre hasta un glóbulo rojo maduro listo para circular, toma alrededor de dos días.
¿Qué Son los Eritrocitos y Por Qué son Vitales?
El Examen de Eritrocitos: Una Ventana a la Salud
La Fábrica de Glóbulos Rojos: La Médula Ósea
La hemoglobina de conejo es una proteína nativa de longitud completa . Esta proteína se purifica a partir de eritrocitos de conejo. Su pureza se determinó mediante SDS-PAGE y alcanzó hasta el 95 %. Presenta una masa molecular de aproximadamente 14,4 kDa, visualizada en el gel.
La hemoglobina de conejo es una proteína nativa de longitud completa . Esta proteína se purifica a partir de eritrocitos de conejo. Su pureza se determinó mediante SDS-PAGE y alcanzó hasta el 95 %. Presenta una masa molecular de aproximadamente 14,4 kDa, visualizada en el gel.
Y la producción es asombrosa. Para mantener un suministro constante y reemplazar las células viejas o dañadas, el cuerpo de un mamífero produce millones de glóbulos rojos cada segundo. Es un testimonio de la increíble capacidad de regeneración y mantenimiento que posee el organismo.
Composición General de la Sangre
Para entender completamente el papel de los eritrocitos, es útil verlos en el contexto de la sangre en su totalidad. La sangre está compuesta por dos partes principales: los elementos celulares (las células) y el plasma (la parte líquida).
Si tomamos una muestra de sangre y la centrifugamos (la hacemos girar muy rápido), los componentes se separan por densidad. En el fondo del tubo, encontraremos una capa roja: son los glóbulos rojos. Encima de esta capa, hay una fina capa blanquecina formada por los glóbulos blancos y las plaquetas. Y en la parte superior, está el líquido amarillento, que es el plasma.
En mamíferos, los glóbulos rojos constituyen la mayor parte de los elementos celulares. La proporción aproximada en una muestra de sangre centrifugada sería algo así:
| Componente | Porcentaje Aproximado | Función Principal |
|---|---|---|
| Eritrocitos (Glóbulos Rojos) | ~45% | Transporte de oxígeno y dióxido de carbono |
| Glóbulos Blancos y Plaquetas | <1% | Defensa inmunitaria y coagulación sanguínea |
| Plasma | ~55% | Transporte de nutrientes, hormonas, proteínas, etc. |
Esta tabla nos muestra visualmente que los eritrocitos son, con diferencia, el tipo de célula más numeroso en la sangre. Su volumen es casi igual al del plasma, lo que subraya su importancia cuantitativa y funcional en el transporte de gases vitales.
Preguntas Frecuentes sobre los Eritrocitos y la Sangre
Aquí respondemos algunas dudas comunes que podrían surgirte sobre los eritrocitos y su papel en la salud de tu conejo:
¿Qué son exactamente los glóbulos rojos?
Son las células más abundantes en la sangre, también llamadas eritrocitos. Contienen hemoglobina y su función principal es transportar oxígeno desde los pulmones a los tejidos y recoger dióxido de carbono para llevarlo de vuelta a los pulmones.
¿Qué mide un examen de eritrocitos?
Mide la cantidad de glóbulos rojos presentes en un volumen de sangre. Es una parte clave de un análisis de sangre general que ayuda a evaluar la capacidad de transporte de oxígeno de la sangre y detectar posibles problemas como anemia.
¿Por qué mi veterinario querría hacerle un examen de eritrocitos a mi conejo?
Los niveles de glóbulos rojos son un indicador importante de la salud general. Un examen puede ayudar a diagnosticar o monitorear condiciones como anemia (bajo recuento), que puede ser causada por diversas razones, desde deficiencias nutricionales hasta enfermedades crónicas o parasitismo. También forma parte de chequeos rutinarios o evaluaciones pre-quirúrgicas.
¿Dónde se fabrican los glóbulos rojos en el cuerpo de mi conejo?
Se producen principalmente en la médula ósea roja, que se encuentra dentro de los huesos. Las células madre en la médula ósea se diferencian y maduran hasta convertirse en eritrocitos funcionales.
¿Qué porcentaje de la sangre son glóbulos rojos?
En mamíferos, incluyendo los conejos, los glóbulos rojos constituyen aproximadamente el 45% del volumen total de la sangre.
Conclusión
Aunque pequeños e invisibles sin un microscopio, los eritrocitos desempeñan un papel gigantesco en mantener a nuestros conejos sanos y activos. Son los incansables transportadores de oxígeno, esenciales para la vida y la energía. Un simple análisis que mide su cantidad puede proporcionar al veterinario información invaluable sobre el bienestar interno de tu mascota. Cuidar la salud de tu conejo implica comprender la importancia de cada uno de los componentes de su "río de la vida", y los glóbulos rojos son, sin duda, uno de los más esenciales.
Si quieres conocer otros artículos parecidos a Eritrocitos: Clave en la Salud de Tu Conejo puedes visitar la categoría Conejos.

